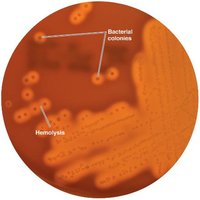
Blood agar, a differential medium

BackMicrobial Growth: Physical and Chemical Requirements, Culture Methods, and Measurement
Study Guide - Smart Notes
Tailored notes based on your materials, expanded with key definitions, examples, and context.
Microbial Growth
Physical Requirements for Microbial Growth
Microorganisms require specific physical conditions for optimal growth. These include temperature, pH, and osmotic pressure, each influencing the rate and extent of microbial proliferation.
Temperature: Microbes are classified based on their preferred temperature ranges:
Psychrophiles: Grow best at cold temperatures (−10°C to 20°C).
Psychrotrophs: Grow between 0°C and 20–30°C; often responsible for food spoilage.
Mesophiles: Thrive at moderate temperatures (20°C to 45°C); most human pathogens are mesophiles.
Thermophiles: Prefer hot environments (50°C to 60°C), such as hot springs and compost heaps.
Hyperthermophiles: Grow optimally above 80°C, often found in extreme environments like hydrothermal vents.

Food Preservation Temperatures: Temperature control is crucial for preventing microbial growth in food. The 'danger zone' (approximately 15°C to 50°C) allows rapid bacterial growth and toxin production.

Cooling Rate and Food Spoilage: The rate at which food cools in a refrigerator affects the risk of spoilage. Larger volumes cool more slowly, increasing the risk of bacterial multiplication.

pH: Most bacteria grow best between pH 6.5 and 7.5. Molds and yeasts prefer slightly acidic conditions (pH 5–6). Acidophiles can thrive in highly acidic environments.
Osmotic Pressure: Microbes are affected by the solute concentration of their environment. Hypertonic solutions cause plasmolysis, inhibiting growth. Some microbes (halophiles) require or tolerate high salt concentrations.

Chemical Requirements for Microbial Growth
Microorganisms need various chemical elements for cellular structure and metabolism.
Carbon: The backbone of all organic molecules. Chemoheterotrophs use organic carbon sources, while autotrophs utilize CO2.
Nitrogen: Essential for proteins, DNA, and ATP. Most bacteria obtain nitrogen by decomposing proteins, using ammonium (NH4+), nitrate (NO3−), or fixing atmospheric N2.
Sulfur: Found in amino acids, thiamine, and biotin. Sources include protein decomposition, sulfate (SO42−), and hydrogen sulfide (H2S).
Phosphorus: Required for nucleic acids, ATP, and membranes. Provided as phosphate (PO43−).
Trace Elements: Inorganic elements (e.g., iron, copper, zinc) needed in small amounts, often as enzyme cofactors.
Oxygen: Microbes vary in their oxygen requirements:
Obligate aerobes: Require oxygen for growth.
Facultative anaerobes: Can grow with or without oxygen (via fermentation or anaerobic respiration).
Anaerobes: Cannot use oxygen; often harmed by it.
Aerotolerant anaerobes: Tolerate oxygen but do not use it.
Microaerophiles: Require low oxygen concentrations.

Organic Growth Factors: Essential organic compounds (e.g., vitamins, amino acids, purines, pyrimidines) that microbes cannot synthesize and must obtain from the environment.
Biofilms
Structure and Importance of Biofilms
Biofilms are complex microbial communities that adhere to surfaces and are embedded in a self-produced matrix of extracellular polymeric substances. They facilitate nutrient sharing, protect microbes from environmental threats, and enable cell-to-cell communication via quorum sensing.
Biofilms are found in natural, industrial, and clinical settings (e.g., digestive system, sewage pipes, catheters).
They are highly resistant to antimicrobial agents and are implicated in a majority of persistent infections.


Culture Media and Growth Techniques
Types of Culture Media
Culture media provide the nutrients required for microbial growth in the laboratory. They can be classified based on their composition and purpose.
Chemically Defined Media: Exact chemical composition is known; used for fastidious organisms and research.


Complex Media: Contain extracts of yeast, meat, or plants; composition varies between batches. Examples include nutrient broth and nutrient agar.

Reducing Media: Used for cultivating anaerobic bacteria; contain chemicals that remove oxygen.


Special Culture Techniques: Capnophiles require high CO2 conditions. Biosafety levels (BSL-1 to BSL-4) dictate laboratory safety protocols based on organism risk.

Selective Media: Suppress unwanted microbes and encourage the growth of desired organisms.
Differential Media: Distinguish between different microbes based on colony appearance or biochemical reactions.

Enrichment Culture: Increases the number of a desired microbe to detectable levels, often used for rare organisms.
Summary Table of Media Types:
Type | Purpose |
|---|---|
Chemically Defined | Growth of chemoautotrophs and photoautotrophs; microbiological assays |
Complex | Growth of most chemoheterotrophic organisms |
Reducing | Growth of obligate anaerobes |
Selective | Suppression of unwanted microbes; encouraging desired microbes |
Differential | Differentiation of colonies of desired microbes from others |
Enrichment | Increase numbers of desired microbes to detectable levels |

Obtaining and Preserving Pure Cultures
A pure culture contains only one species or strain. The streak plate method is commonly used to isolate pure colonies from a mixed sample. Preservation methods include deep-freezing and lyophilization (freeze-drying).

Bacterial Division and Growth
Mechanisms of Bacterial Division
Bacterial growth refers to an increase in cell number, not cell size. Most bacteria reproduce by binary fission, but some use budding, conidiospore formation, or filament fragmentation.


Generation Time and Growth Curves
The generation time is the period required for a cell to divide. Binary fission results in exponential population growth, described by the equation:
where is the final number of cells, is the initial number, and is the number of generations.



Phases of Bacterial Growth
Bacterial populations in batch culture exhibit four distinct growth phases:
Lag Phase: Cells adapt to new environment; little or no cell division.
Log (Exponential) Phase: Rapid cell division and population growth.
Stationary Phase: Growth rate slows; equilibrium between cell division and death due to nutrient depletion or waste accumulation.
Death Phase: Number of dying cells exceeds new cells formed; population declines.

Measuring Microbial Growth
Direct Measurement Methods
Plate Count: Counts colonies on agar plates; requires serial dilution to obtain countable numbers (30–300 CFUs per plate).


Filtration: Used for small microbial populations; bacteria are trapped on a filter, then transferred to a medium for colony growth.

Most Probable Number (MPN) Method: Statistical estimation based on dilution series and positive growth tubes.


Direct Microscopic Count: Uses a Petroff-Hausser cell counter to count cells in a defined volume under a microscope.

Indirect Measurement Methods
Turbidity: Measures cloudiness of a culture with a spectrophotometer; higher turbidity indicates more cells.
Metabolic Activity: Estimates cell numbers based on the amount of metabolic product formed.
Dry Weight: Used for filamentous organisms; cells are filtered, dried, and weighed.
